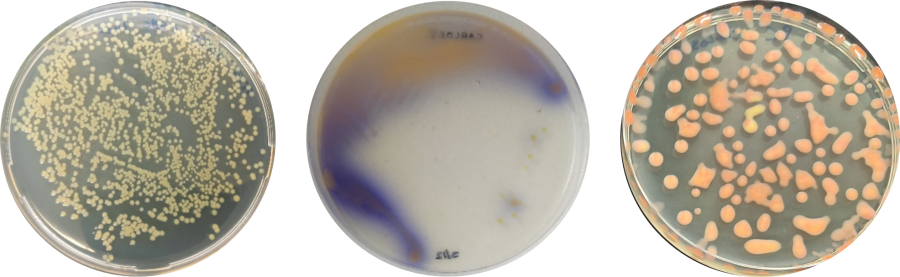
Cff op kweekmedium

Nieuws Curtobacterium flaccumfaciens pv. flaccumfaciens in peulgewassen op de radar: reden tot bezorgdheid?
Curtobacterium flaccumfaciens pv. flaccumfaciens, kortweg Cff, is een beruchte ziekmaker van peulgewassen zoals bonen en soja. In Europa was deze bacterie lange tijd vrijwel onbekend, terwijl ze in Noord-Amerika al meer dan een eeuw schade aanricht in de teelt van bonen met een duidelijke heropleving sinds het einde van de 20e eeuw (zie deze plantenpester). In Europa kwam Cff in 2019 plotseling in de schijnwerpers te staan toen het als volwaardig quarantaine-organisme werd opgenomen in de Europese Plantengezondheidswet. Sindsdien moeten alle lidstaten maatregelen nemen om te voorkomen dat Cff in de EU wordt binnengebracht en zich verspreidt. Naar aanleiding van enkele vaststellingen van Cff in de EU en de onderschepping van besmette zaadpartijen uit de Verenigde Staten werden de invoereisen voor zaden recent flink aangescherpt, met speciale aandacht voor het testen op Cff voordat de zaden naar de EU worden geëxporteerd. Daarnaast verplicht de EU alle lidstaten nu om elk jaar veldonderzoek te doen naar de aanwezigheid van de bacterie op hun grondgebied. Dit heeft de voorbije maanden geleid tot toenemende alertheid binnen de sector van de vlinderbloemige teelten.
Wat is Cff en waar komt het voor?
Curtobacterium is een staafvormige bacterie die in vrijwel elk natuurlijk ecosysteem op aarde voorkomt, vooral op planten en in de bodem. Sommige soorten kunnen planten aantasten, maar voor mens en dier zijn ze geheel onschadelijk. Cff, de Curtobacterium waarover dit artikel gaat, staat bekend als ziekmaker of pathogeen van peulvruchten (Fabaceae), en in het bijzonder van Phaseolus bonen.
In het laboratorium valt Cff op door z’n opvallende kleurenpalet. Op kweekmedia kunnen de kolonies geel, geel met vorming van paars pigment, oranje, zalmkleurig of rood zijn, waardoor de bacterie ook wel de “veelkleurige bacterie” wordt genoemd (Foto 1).
Cff werd voor het eerst beschreven in 1922 in Phaseolus boon in de VS. De ziekte is er nog steeds aanwezig, vooral op de centrale hoogvlakten (o.a. Nebraska). Sindsdien werden ook economische verliezen opgemeten in Brazilië op Phaseolus boon en soja (Glycine max), in Iran op Phaseolus boon en cowpea (Vigna unguiculata), en in Oost-Australië op mungboon (Vigna radiata).
In Europa werd de bacterie tot nu toe slechts sporadisch aangetroffen. In 2001 en 2005 waren er enkele geïsoleerde meldingen van besmette Phaseolus zaden en planten in Spanje. In 2011 werd Curtobacterium geïsoleerd uit symptomatische sojaplanten in een rassenproef in Duitsland. In 2018 waren mungboon planten en zaden positief in Oostenrijk. Meer recent, in 2024, werden enkele Phaseolus veldteelten en het bijbehorende zaaizaad in Nederland en Zwitserland besmet bevonden, terwijl in Griekenland datzelfde jaar de bacterie in bonenzaad werd gedetecteerd. Net buiten Europa is Curtobacterium in beperkte mate aanwezig in Turkije en Rusland.
Ook in België is Cff inmiddels aangetroffen. In 2021 werd de pathogeen eerder bij toeval geïsoleerd uit Vicia faba planten (veldboon) met symptomen van Botrytis fabae, en in 2024 opnieuw uit symptomatische Phaseolus planten tijdens een onderzoek naar het voorkomen van de bacterie in rassenproeven met vlinderbloemige teelten. In 2025, tijdens de eerste uitvoering van de nationale survey door het FAVV (opgelegd door de EU), testten twee asymptomatische Phaseolus monsters uit het veld eveneens positief. In elk van de gevallen van 2024 en 2025 bleek de oorsprong van de besmetting te liggen bij gecontamineerd zaaigoed uit de VS.
Hoe schadelijk is Cff en hoe verspreidt het zich?
Besmet zaaizaad vormt de belangrijkste route voor insleep van Cff in de EU. Vanuit het zaad dringt de bacterie door in de watervoerende kanalen van de plant (= het vasculaire weefsel), waar ze zich verder verspreidt. Bij Phaseolus bonen zijn de eerste symptomen vaak subtiel: slappe bladranden en lichtgroene verkleuringen in het blad. Die evolueren tot bruine vlekken met een verbrand uitzicht, meestal omgeven door een gele rand. Dit typische symptoom staat bekend als “firing” (Foto 2). Uiteindelijk verdrogen de aangetaste bladeren en vallen ze af. In ernstige gevallen kunnen planten volledig afsterven, met een aanzienlijke opbrengstvermindering tot gevolg. In soja wordt de aantasting meestal waargenomen als “tan spot” op de bladeren, naar het uitzicht van zonnevlekken. Omdat Cff symptomen sterk kunnen lijken op droogtestress of aantastingen door andere pathogenen, wordt de ziekte niet altijd meteen herkend.

Naast de primaire besmetting via zaad kunnen ook secundaire infecties optreden. Cff kan zich namelijk van plant tot plant verspreiden via contact (bijvoorbeeld via gereedschap) of via water (zoals irrigatie over het gewas). De bacterie dringt daarbij het vasculaire systeem van de plant binnen via natuurlijke openingen of kleine wondjes.
De grootste schade treedt op in regio’s waar de omstandigheden gunstig zijn voor de ontwikkeling van de bacterie: langdurige periodes van warm weer (>30 °C) in combinatie met droogte. Hierdoor komen de bonenplanten onder stress te staan, wat ze gevoeliger maakt voor aantasting door Cff. Bovendien wordt onder zulke omstandigheden vaak beregend, wat de verspreiding van de bacterie bevordert. Onder onze huidige klimaatcondities zijn dergelijke stresssituaties vooralsnog beperkt, waardoor besmettingen vaak onopgemerkt blijven.
Wat zijn de consequenties als Cff wordt vastgesteld in België?
Het gebruik van gezond zaaizaad is essentieel voor een gezond gewas, en dat geldt zeker voor Cff. Dankzij de verscherpte controles op de invoer van zaaizaad is de kans op introductie van Cff eerder klein. Wordt de bacterie toch vastgesteld, dan geldt een meldingsplicht bij het Federaal Agentschap voor de Veiligheid van de Voedselketen (FAVV) en moeten er specifieke maatregelen getroffen worden.
Zo moeten de planten in het besmette gebied zo snel mogelijk worden ondergewerkt. Gedurende de rest van het jaar en minimaal de twee daaropvolgende kalenderjaren mogen er geen vlinderbloemigen worden geteeld in de betreffende zone. Eventuele hergroei van het gewas moet gedurende die periode steeds worden verwijderd om te voorkomen dat de bacterie kan overleven. Na twee jaar wordt aangenomen dat er geen levensvatbare bacteriecellen meer aanwezig zijn. Gewassen uit bedekte teelt kunnen ook worden afgevoerd en vernietigd door verbranding, biomethanisatie of industriële compostering, mits goedkeuring van de bevoegde instanties. In dat geval kan het teeltverbod worden beperkt tot één kalenderjaar na het jaar van besmetting. Wordt bovendien de bodem gestoomd of worden substraatmatten gestoomd of vervangen, dan mogen er in het volgende kalenderjaar al opnieuw Fabaceae worden geteeld na grondige ontsmetting van de locatie.
Is het gewas op het moment van de vaststelling van de bacterie al oogstklaar, dan mogen er voor de vernietiging van het gewas nog onrijpe peulen worden geoogst, maar enkel voor directe verwerking in de voedingsindustrie (conserveren of diepvries). Al het afval van het industriële proces moet zorgvuldig worden afgevoerd en gedecontamineerd via de hierboven beschreven methoden en het proceswater moet worden behandeld via een waterzuiveringsinstallatie.
Wordt Cff aangetroffen in een partij zaaizaad, dan moet deze partij volledig worden vernietigd. Als het zaad al is uitgezaaid, moet het gewas nauwgezet worden gemonitord. Enkel wanneer geen symptomen worden vastgesteld, mag het gewas verder afrijpen en geoogst worden voor rechtstreekse levering aan de industrie of voor afzet via veiling of groothandel. Daarbij geldt wel dat herbruikbare kratten nadien grondig moeten worden gedesinfecteerd. Voor verwerking van de oogstresten en het teeltverbod gelden dezelfde regels als voor besmette teelten. In geen van bovenstaande scenario’s mag zaad worden geoogst met het oog op gebruik als zaaizaad.
Wat doet ILVO?
Sinds de update van de quarantainestatus van Cff in de Europese Plantengezondheidswet lopen er bij het bacteriologielabo van ILVO verschillende projecten rond deze bacterie. ILVO is één van de stichtende partners van het Europees Referentielaboratorium (EURL) voor plantpathogene bacteriën. Binnen dit Europese netwerk spelen we een voortrekkersrol in het valideren en ter beschikking stellen van gestandaardiseerde diagnostische methoden voor Cff, waaronder specifieke testen voor de opsporing van de bacterie in bonenzaad (Foto 3). Deze methoden worden routinematig toegepast in ons onderzoekslaboratorium en ook in ons Diagnosecentrum voor Planten (DCP). Binnen het DCP analyseren we onder andere de monsters die door het FAVV worden genomen in het kader van het officiële monitoringprogramma voor Cff. Dit omvat zowel stalen van nationale surveys als importcontroles.

Daarnaast voert ILVO, in samenwerking met de Waalse onderzoeksinstelling CRA-W, het CurtoALERT-project uit, dat wordt gesubsidieerd door de Belgische Federale Overheidsdienst Volksgezondheid, Veiligheid van de Voedselketen en Leefmilieu. Dit project richt zich op het in kaart brengen van het voorkomen van Cff in België. Hiertoe worden zowel vlinderbloemige gewassen als zaadpartijen in Vlaanderen en Wallonië gesurveyd, en worden de diagnostische methoden verder verfijnd. Bovendien wordt experimenteel onderzocht hoe gevoelig verschillende Phaseolus genotypes zijn voor de bacterie.
Een belangrijke vaststelling uit het project is dat het Cff besmettingsniveau in gecontamineerde zaadpartijen doorgaans laag is. Wanneer de bacterie van het zaad naar de plant wordt overgedragen, blijft de ontwikkeling van ziektesymptomen bovendien zeer beperkt onder Belgische klimaatomstandigheden. Deze inzichten zijn cruciaal voor een onderbouwde risicoanalyse en helpen om toekomstige beheersmaatregelen beter af te stemmen op de reële situatie.
Wil je meer lezen over ons onderzoek rond het voorkomen van Cff in België? Dat kan hier.
 Diagnosecentrum voor Planten
Diagnosecentrum voor Planten